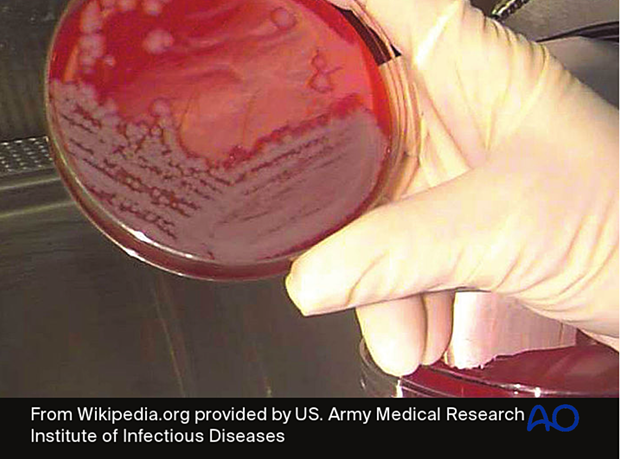
Infecting microorganisms should be identified, their antibiotic sensitivities defined, and appropriate specific antibiotics ...

Like all infections, those involving fracture wounds can be classified according to the infecting organism(s). Adequate specimens, taken at surgery from several representative locations and properly processed with Gram’s stain and cultures by the microbiology laboratory, are necessary to identify the causative organism(s) and antibiotic sensitivities. Special sensitivity testing may be necessary, particularly with potentially resistant organisms.
The most common microorganism causing post-traumatic infection is gram-positive staphylococci. Worldwide, methicillin-sensitive Staphylococcus aureus (MSSA) is most common. In some areas, methicillin-resistant Staphylococcus aureus (MRSA) is a significant problem, particularly for postoperative infections and institutionalized patients.
The possible presence of a drug-resistant bacterial strain must be considered during diagnosis and treatment of infection.
Gram-negative bacilli occur in 10% of infections, usually with open fractures and hospital-acquired infection. Polymicrobial, or mixed, infections (25%-30%) are actually more common, and may require prolonged, complex treatment.
Remember that culture-specific infections may become polymicrobial, leading to challenges in proper antibiotic selection.
Although antibiotics are a valuable adjunct to the treatment of post-traumatic infections, adequate surgical debridement is essential for effective treatment. Macroscopic quantities of bacteria are removed by surgical debridement. Antibiotic administration suppresses bacterial growth and helps eliminate bacteria at the microscopic level.
Unless a patient is overtly septic with a systemic, life-threatening infection, it is advantageous to obtain cultures before beginning antibiotics, to maximize the likelihood of correct identification and sensitivity-testing of bacterial pathogens.

Infecting microorganisms should be identified, their antibiotic sensitivities defined, and appropriate specific antibiotics administered as an adjunct to surgical treatment. It is now appreciated that infecting micro-organisms can either be adherent to surrounding tissues or free in the wound tissues and fluids. Those that are free, and therefore likely to be detectable by standard culture techniques, are called planktonic micro-organisms.
Many of the bacteria that inhabit chronic wounds set up complex polymicrobial biofilm communities that can only be detected by culture techniques when a sufficient quantity of planktonic cells that can be grown on conventional culture media is obtained.
A major problem in bony infections is the fact that biofilm or adherent bacteria cannot be recovered by standard culture techniques, which means that intraoperative specimens often yield negative culture results even when multiple clinical signs point to infection. If infected hardware is removed, sonication can be used to detach adherent bacteria, which can then be grown in culture media.
